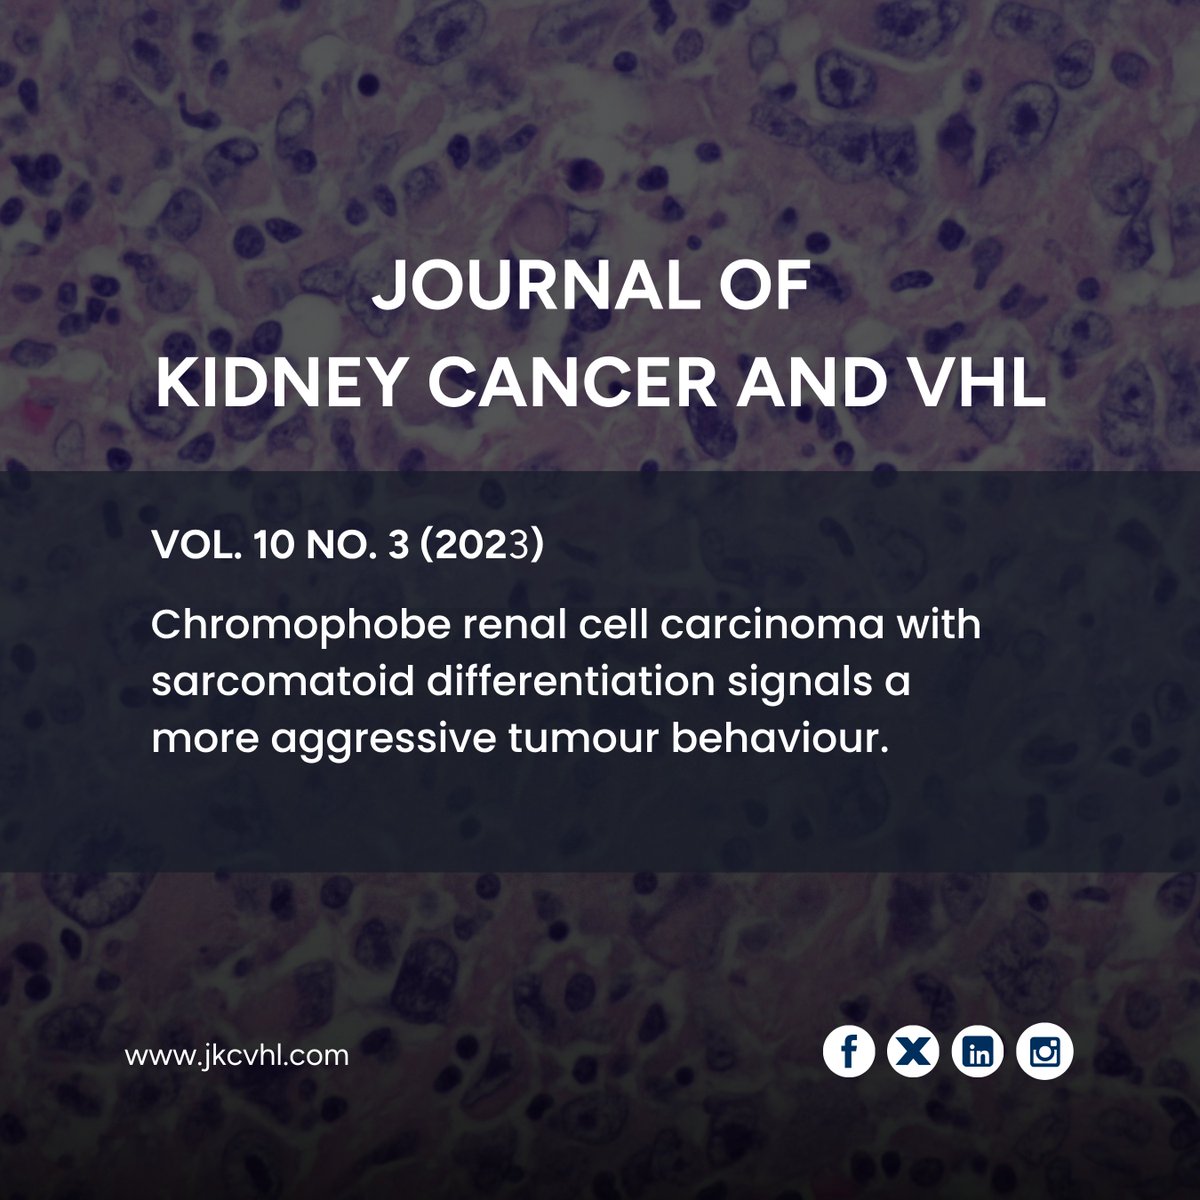
Journal of Kidney Cancer and VHL tweet media

Kidney tumour location affects surgical planning—posterior vs. antero-lateral tumours pose different challenges in retroperitoneal laparoscopic partial nephrectomy, guiding the choice of approach.
Read more: jkcvhl.com/index.php/jkcv…
#KidneyCancer #RCC #UrologicSurgery
English